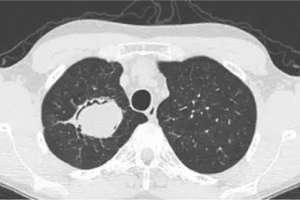

Author Affiliations
Abstract
Aspergilloma, also known as Aspergillus fungus ball or mycetoma, is a rare disease. A fungal infection is the cause of Chronic Pulmonary Aspergillosis (CPA), a debilitating lung disease that primarily affects people who have had previous or concurrent pulmonary conditions. CPA is indeed less common in the United States. Estimates suggest that approximately 400,000 people in the world who have allergic bronchopulmonary aspergillosis (ABPA) also have CPA. Although there are several culture non-culture-based techniques available, diagnosis is still a challenge. Aspergilloma treatment options include antifungal medication, bronchodilation therapy to open airways, and surgical removal of the infected tissue. It may be advised to observe and keep a close eye on things in certain situations. The patient’s general health and the specific circumstances of each case determine the treatment strategy. Herein, we report the case of an elderly man with massive hemoptysis and a medical history of resolved pulmonary tuberculosis and HIV. Vital signs and laboratory investigations were normal. Crescent sign and Halo sign were found in chest computed tomography (CT) scan. The patient was treated with antifungal medication.
Keywords
Aspergilloma, Chronic Pulmonary Aspergillosis, Lung disease, Fungal infection, Hemoptysis, CT scan, Antifungal treatment
Introduction
CPA is a severe lung disease resulting from a fungal infection due to Aspergillus species (usually Aspergillus fumigatus), primarily impacting individuals with pre-existing or concurrent pulmonary conditions. While its global prevalence stands at 42 cases per 100,000 population, in the United States and Europe, it is less than 1 case per 100,000 [1]. An aspergilloma is a ball or mycetoma composed of Aspergillus hyphae, cellular debris, and mucus. Risk factors include pre-existing lung conditions such as pulmonary tuberculosis, cystic fibrosis, bronchiectasis, pneumoconiosis, and sarcoidosis, as well as immunosuppression due to conditions like Human immunodeficiency virus (HIV), chemotherapy, neutropenia, and chronic diseases such as Chronic obstructive pulmonary disease (COPD) and chronic liver disease [1].
Aspergillomas can also occur in solid organs like the brain and kidneys. The most common clinical sign in symptomatic patients is hemoptysis due to blood vessel invasion. However, patients are usually asymptomatic until the disease is advanced. In some cases, fever, shortness of breath, weight loss, and fatigue may occur [3]. Proved disease requires histopathologic, cytopathologic, or direct microscopic confirmation of tissue invasion. Different diagnosis techniques were used, such as staining, polymerase chain reaction, chest X-ray, Contrast-enhanced computed tomography (CECT), Echocardiography, Enzyme Linked Immunosorbent Assay (ELISA), and biopsy [4]. If the organism invades the surrounding parenchyma, recurrent pneumonia, chronic cough, or pulmonary fibrosis can occur. Although mycetoma is more common in immunocompetent patients with prior lung disease, invasive aspergillus infections are more frequent in immunocompromised individuals. Individuals who have immunosuppressive conditions like diabetes are more prone to developing pulmonary aspergilloma and face a higher risk of mortality [5]. Currently, several antifungal treatment options are available. Although isavuconazole and posaconazole have comparable efficacy and less toxicity, voriconazole is still the preferred treatment. When there is severe immunosuppression and widespread infection, combination therapy is employed [1].
This paper illustrates the case of aspergilloma in a 65-year-old man, detailing clinical manifestations, imaging studies, and management.
Case Presentation
A 65-year-old man visited the physician’s office with a complaint of hemoptysis. He reported having a productive cough with yellowish sputum for the past five days, accompanied by shortness of breath and mild fatigue on exertion. He occasionally witnessed slight streaks of blood in his sputum. He had no fever, chills, night sweats, or weight loss. The patient’s medical history was significant for resolved pulmonary tuberculosis and HIV, which have been under antiretroviral therapy since last year. He had a smoking history of 45 pack-years and consumed alcohol on weekends. On physical examination, mild diffuse wheezing was heard. His vital signs were blood pressure of 136/88 mmHg, a pulse of 102/min, respirations of 18/min, and SpO2 of 91% on room air. Laboratory investigations revealed normal complete blood count results, such as hemoglobin (13.4 g/dL), leukocyte count (10,800/mm3), and normal platelet count (172,000/μL). A chest CT scan was ordered, and the results are shown in the exhibit (Figure 1).
Figure 1: CT Chest
The CT scan revealed several distinctive findings: a solid spherical lesion within the cavity space, an air crescent sign separating a portion or all of the fungal ball from the cavity wall (also observed in conditions like lung abscess, bladder cyst, and granulomatosis with polyangiitis), a Halo sign indicating inflammation surrounding the cavity wall, and a Monod sign, which involves positional changes of the fungal ball relative to the cavity, influenced by patient positioning during imaging. The presence of aspergillus filaments was confirmed by sputum staining.
Case Management
The patient received oral voriconazole at a dose of 200 mg once daily for a month along with supportive therapy (bronchodilators). Observation and close monitoring are recommended after one month. He was advised to take preventive measures to avoid exposure to a soil and dust environment. He was also advised to ensure adequate hydration and monitor for signs of anemia or respiratory compromise. Follow-up visits are recommended regularly for monitoring symptoms, imaging findings, and response to treatment or stability of the condition.
Discussion
Aspergillus species-related diseases primarily impact immunocompromised patients and present with a wide range of clinical symptoms, including manifestations inside the lungs. Aspergillomas, which are mycelial balls growing in damaged lung areas like cavities, are one way local pulmonary disease manifests itself [6]. Diagnosis of aspergilloma is typically based on clinical presentation and imaging studies such as chest X-rays and CT scans. Common symptoms of the lower respiratory tract include fever, wheezing, respiratory distress, and coughing up phlegm or not. Particularly in patients who are neutropenic, Aspergillus tends to invade the vasculature, which can result in necrosis, thrombosis, and tissue infarction. Hemoptysis and pleuritic chest pain may be present in such circumstances [3].
Along with Aspergillus and the relationship between diabetes control and the risk of infection with aspergilloma, disease complications, and antifungal therapy (drug-induced hepatitis), the clinical presentation (symptoms and signs), comorbidities such as T2DM, investigations (lab and radiology), treatment response, and follow-up were compared in the local and international literature. Other species that can cause diseases include Aspergillus flavus, Aspergillus niger, and Aspergillus terreus. Aspergillus fumigatus is the most common cause of pulmonary disease [7]
Jiang C et al reviewed 100 cases of complex aspergilloma and 66 cases of simple aspergilloma. They found that patients with complex diseases 72 experienced hemoptysis, while 35 had simple diseases. 42 patients with simple aspergillomas underwent video-assisted thoracoscopic surgery, while 75 patients with complex aspergillomas underwent thoracotomy. The most frequent postoperative complication was prolonged air leakage (>7 days). In one patient, a bronchopleural fistula developed after surgery. After surgery, one patient passed away from respiratory failure 30 days later. A recurrence occurred in 2 of the patients during follow-up. For both complex and simple aspergillomas, the overall 10-year survival rates were 94.97% and 87.7%, respectively [8].
Hernández-Solís A et al concluded that patients who have compromised immune systems are highly susceptible to pulmonary aspergilloma, with hemoptysis being the most common clinical manifestation. In addition to needing an efficient treatment to combat this illness, health professionals must have a high index of clinical suspicion to make an accurate and timely diagnosis [9].
Pneumonostomy and myoplasty were used by Gebitekin et al. to treat complex aspergilloma, and itraconazole was taken orally two weeks prior to and three months following surgery. The findings demonstrated the complete removal of aspergillomas with minimal postoperative complications and no fatalities [10]. Nonetheless, postoperative adjuvant medication therapy did not enhance the prognosis in the Sagan et al. study. Patients who are contraindicated or who refuse surgery may try percutaneous or bronchoscopic injection of antifungal agents because systemic antifungal agents have trouble penetrating the aspergillus globule cavity [11].
Chen X et al carried out a single-center, randomized, parallel grouping, prospective, two-year clinical study. The purpose of this research was to assess the safety of antifungal medications and the difference in recurrence risk in patients with pathologically confirmed aspergilloma following surgery. By monitoring the quality of life, lung function, safety of fungal treatment, and recurrence of aspergilloma closely, one can determine the best course of treatment for the disease, enhance patients’ quality of life, lessen the likelihood of aspergillus infection recurring, and ultimately improve the prognosis of aspergilloma patients. The study’s findings will offer superior evidence-based medical data for the development, modification, and enhancement of national and international clinical guidelines as well as expert consensus on chronic aspergillus lung disease. [12].
Ray A et al demonstrated that 235 per-protocol analyses evaluating the treatment of patients with pulmonary aspergilloma revealed that nebulized amphotericin B (nAB) was not inferior to oral itraconazole. While there was a slight cough during nebulization, it was well tolerated. The role of nAB at different doses and frequencies in the treatment of pulmonary aspergilloma should be investigated in larger studies [13].
Ruby, L. C et al stated that sonographic results matched the patient’s computed tomography and chest X-ray images as well as previously documented sonographic features of mycotic abscesses in alternate organs. As a point-of-care imaging tool and in situations where other imaging modalities are unavailable, lung ultrasonography may be useful in the diagnosis of pulmonary aspergilloma [14].
Conclusion
Aspergilloma remains a significant health concern in developing nations. Aspergillus infection, which frequently comes before pulmonary tuberculosis, is the cause of pulmonary aspergilloma. Surgical and non-surgical treatments are still difficult to achieve. For most patients, voriconazole is the recommended course of treatment; however, isavuconazole and posaconazole are also significant substitutes. The treatment approach depends on the individual case and the overall health of the patient.
References
- Zarif A, Thomas A, Vayro A. Chronic pulmonary aspergillosis: A brief review. Yale J Biol Med. 2021;94(4):673-679. Chronic pulmonary aspergillosis: A brief review
- Passera E, Rizzi A, Robustellini M, et al. Pulmonary aspergilloma: Clinical aspects and surgical treatment outcome. Thorac Surg Clin. 2012;22(3):345-361. doi.10.1016/j.thorsurg.2012.04.001 PubMed | Crossref | Google Scholar
- Kosmidis C, Denning DW. The clinical spectrum of pulmonary aspergillosis. Thorax. 2015;70(3):270-277. doi.10.1136/thoraxjnl-2014-206291 PubMed | Crossref | Google Scholar
- Russo A, Tiseo G, Falcone M, Menichetti F. Pulmonary aspergillosis: An evolving challenge for diagnosis and treatment. Infect Dis Ther. 2020;9(3):511-524. doi.10.1007/s40121-020-00315-4 PubMed | Crossref | Google Scholar
- Taccone FS, Van den Abeele AM, Bulpa P, et al.; AspICU Study Investigators. Epidemiology of invasive aspergillosis in critically ill patients: Clinical presentation, underlying conditions, and outcomes. Crit Care. 2015;19(1):7. doi.10.1186/s13054-014-0722-7 PubMed | Crossref | Google Scholar
- Barnes PD, Marr KA. Aspergillosis: Spectrum of disease, diagnosis, and treatment. Infect Dis Clin North Am. 2006;20(3):545-561. doi.10.1016/j.idc.2006.06.001 PubMed | Crossref | Google Scholar
- Zanganeh E, Zarrinfar H, Rezaeetalab F, et al. Predominance of non-fumigatus Aspergillus species among patients suspected to pulmonary aspergillosis in a tropical and subtropical region of the Middle East. Microb Pathog. 2018;116:296-300. doi.10.1016/j.micpath.2018.01.047 PubMed | Crossref | Google Scholar
- Jiang C, Dai J, Bao Y, et al. Surgical treatment of pulmonary aspergilloma: A 13-year experience from a single clinical center. Ann Thorac Surg. 2022;114(1):311-318. doi.10.1016/j.athoracsur.2021.06.074
PubMed | Crossref | Google Scholar - Hernández-Solís A, Álvarez-Maldonado P, Araiza-Santibáñez J, et al. Pulmonary aspergilloma in immunocompromised patients in a respiratory care unit. J Infect Dev Ctries. 2022;16(3):564-569. doi.10.3855/jidc.13120 PubMed | Crossref | Google Scholar
- Gebitekin C, Sami Bayram A, Akin S. Complex pulmonary aspergilloma treated with single-stage cavernostomy and myoplasty. Eur J Cardiothorac Surg. 2005;27(5):737-740. doi.10.1016/j.ejcts.2005.02.008
PubMed | Crossref | Google Scholar - Sagan D, Goździuk K. Surgery for pulmonary aspergilloma in immunocompetent patients: No benefit from adjuvant antifungal pharmacotherapy. Ann Thorac Surg. 2010;89(5):1603-1610. doi.10.1016/j.athoracsur.2010.02.037. PubMed | Crossref | Google Scholar
- Chen X, Zhou Y, Zhang L, et al. The effects of antifungal therapy on the recurrence of Aspergillus infection after pulmonary aspergilloma resection: A study protocol for a single-center, prospective, non-blind, randomized, 24-month, parallel group study. BMC Pulm Med. 2021;21(1):335. doi.10.1186/s12890-021-01702-4. PubMed | Crossref | Google Scholar
- Ray A, Manikanta J, Singh K, et al. An open-label non-inferiority randomized control trial comparing nebulised amphotericin B with oral itraconazole in patients with pulmonary aspergilloma. Mycoses. 2021;64(9):1038-1044. doi.10.1111/myc.13329 PubMed | Crossref | Google Scholar
- Ruby LC, Kadavigere R, Sheshadri S, et al. Pulmonary aspergilloma on transthoracic ultrasound. Infection. 2021;49(6):1337-1340. doi.10.1007/s15010-021-01589-7 PubMed | Crossref | Google Scholar
Acknowledgments
Not applicable
Funding
Not applicable
Author Information
Corresponding Author:
Raziya Begum Sheikh
Independent Researcher, Department of Content
medtigo India Pvt Ltd, Pune, India
Email: [email protected]
Co-Author:
Rupashi Mukhia
Department of Outcomes Research
Anesthesiology Institute, Cleveland Clinic, USA
Authors Contributions
All patient-related data were collected by Dr. Rupashi Mukhia. Raziya Begum Sheikh contributed to the writing of the manuscript, including the original draft preparation and subsequent review and editing to refine the final version.
Informed Consent
Not applicable
Conflict of Interest Statement
This case report is based on a clinical case published in the “Cases” section of medtigo.com. The authors declare no conflicts of interest related to this publication.
Guarantor
Not applicable
DOI
Cite this Article
Begum RS, Rupashi M. How Rare is Chronic Pulmonary Aspergillosis. medtigo J Med. 2024;2(2):e3062224. doi:10.63096/medtigo3062224 Crossref

